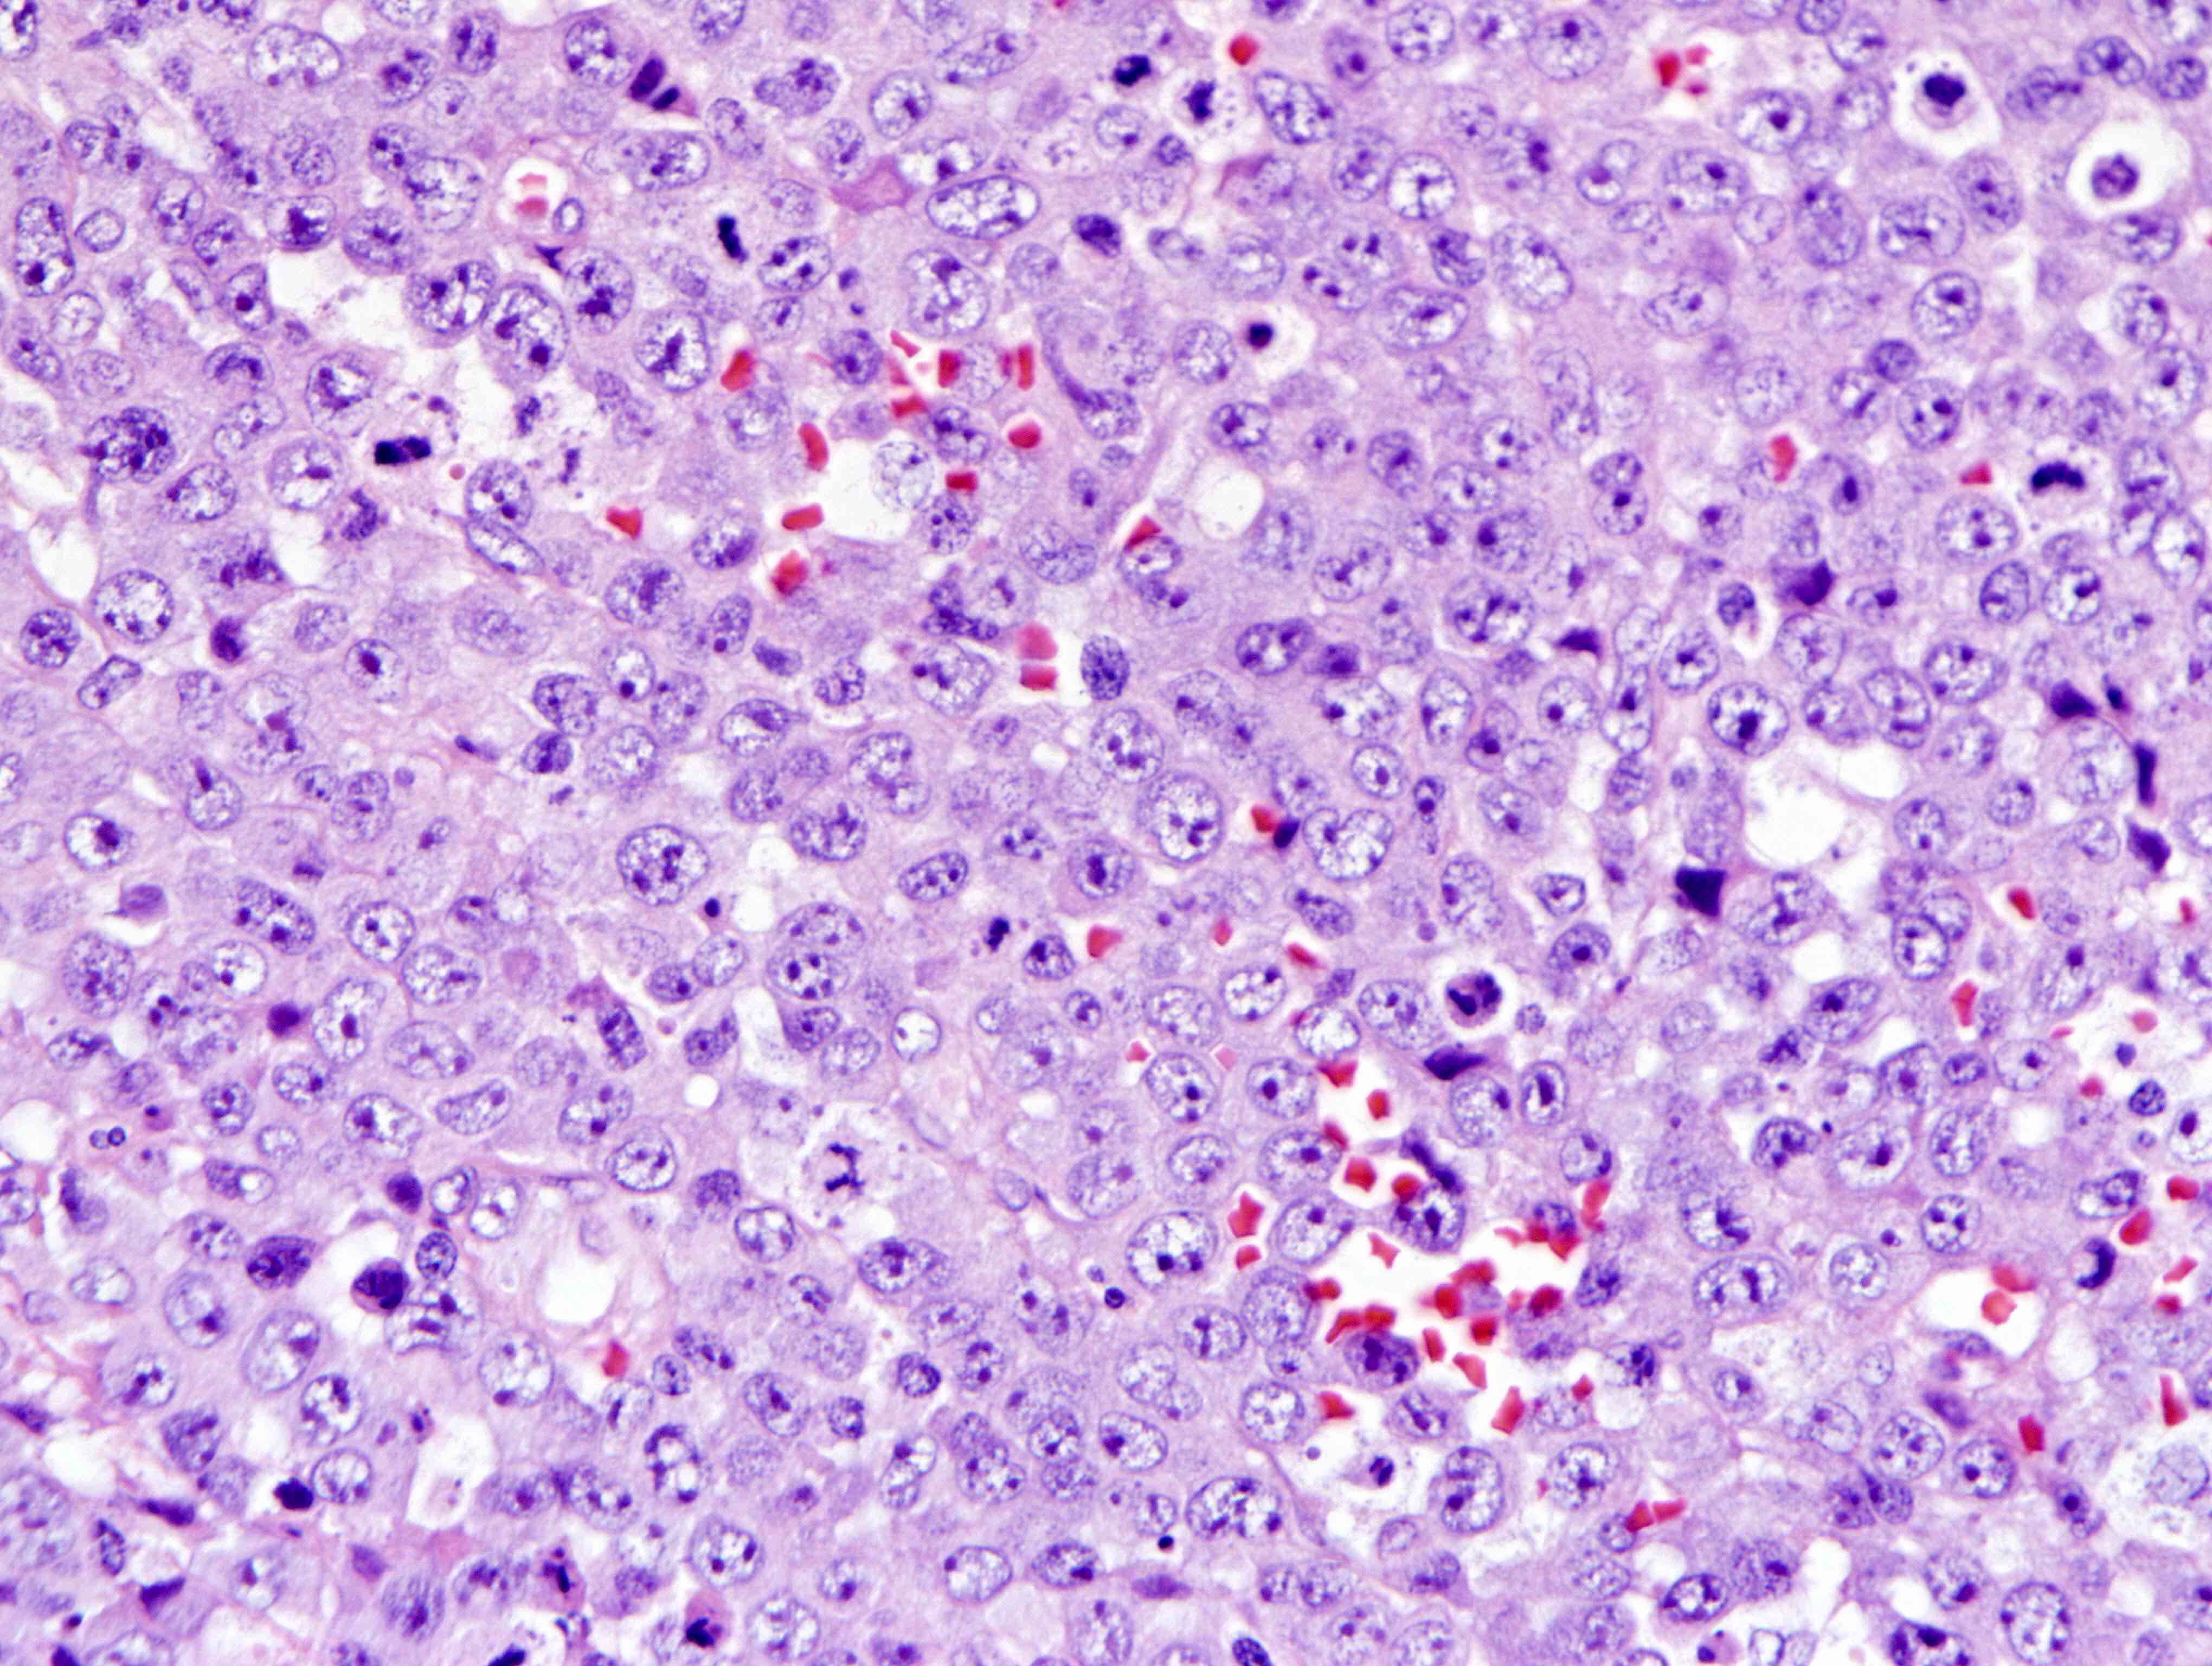

Table of Contents
Definition / general | Essential features | Terminology | ICD coding | Epidemiology | Sites | Pathophysiology | Etiology | Clinical features | Diagnosis | Laboratory | Radiology description | Prognostic factors | Case reports | Treatment | Gross description | Microscopic (histologic) description | Microscopic (histologic) images | Virtual slides | Cytology description | Cytology images | Positive stains | Negative stains | Flow cytometry description | Flow cytometry images | Molecular / cytogenetics description | Molecular / cytogenetics images | Sample pathology report | Differential diagnosis | Additional references | Practice question #1 | Practice answer #1 | Practice question #2 | Practice answer #2Cite this page: Balakrishna J, Jaffe ES. Anaplastic large cell lymphoma, ALK negative. PathologyOutlines.com website. https://www.pathologyoutlines.com/topic/lymphomanonbanaplasticneg.html. Accessed September 16th, 2025.
Definition / general
- A CD30 positive T cell neoplasm morphologically similar to ALK positive anaplastic large cell lymphoma (ALCL) but does not express ALK protein (Swerdlow: WHO Classification of Tumours of Haematopoietic and Lymphoid Tissues, 4th Edition, 2017)
Essential features
- T cell lymphoma
- Characteristic hallmark cells
- Morphologically indistinguishable from ALCL, ALK positive
- CD30 diffusely and strongly positive
- ALK expression negative
- ALK gene rearrangement negative
Terminology
- ALK- ALCL
ICD coding
- ICD-10:
- C84 - mature T / NK cell lymphomas
- C84.7 - anaplastic large cell lymphoma, ALK negative
- C84.70 - unspecified site
- C84.71 - lymph nodes of head, face and neck
- C84.72 - intrathoracic lymph nodes
- C84.73 - intra-abdominal lymph nodes
- C84.74 - lymph nodes of axilla and upper limb
- C84.75 - lymph nodes of inguinal region and lower limb
- C84.76 - intrapelvic lymph nodes
- C84.77 - spleen
- C84.78 - lymph nodes of multiple sites
- C84.79 - extranodal and solid organ sites
Epidemiology
- Adults (40 - 65 years), in contrast to ALCL, ALK+, which is common in children and young adults
- Slight male predominance; M:F = 1.5:1
- Prevalence unknown (Orphanet: ALK Negative Anaplastic Large Cell Lymphoma [Accessed 9 April 2020])
Sites
- Both lymph nodes and extranodal sites, including bone, soft tissue and skin (primary cutaneous ALCL needs to be distinguished)
Pathophysiology
- Arises from activated T cells
- T cell associated antigens often downregulated, with loss of CD3 and other markers
- Gene expression shows common features between ALK+ and ALK- ALCL (Leukemia 2009;23:2129, Blood 2014;123:2915)
- Gains of the 1q41-qter and 6p21 are common cytogenetic aberrations (Br J Haematol 2008;140:516)
- DUSP22::IRF4 locus on 6p25.3 (referred to as DUSP22 rearrangements); t(6;7)(p25.3;q32.3) (Blood 2011;117:915)
- Recurrent rearrangement involving the TP63 gene (Blood 2012;120:2280)
- STAT3 activating mutations (Cancer Cell 2015;27:516)
Clinical features
- Mostly presents at advanced stage (stage III - IV) and B symptoms
Diagnosis
- Biopsy of the involved lymph node with immunohistochemistry
- Morphology (see Microscopic description)
- Immunophenotype (see Positive stains)
- Detection of genetic aberrations and T cell clone (see Molecular / cytogenetics description)
Laboratory
- Elevated lactate dehydrogenase, pancytopenia, anemia, thrombocytopenia (Blood 2008;111:5496)
Radiology description
- Enlarged lymph nodes / mass lesions in extranodal sites
Prognostic factors
- Outcome poorer than ALCL, ALK positive (Histopathology 2003;43:462, J Pathol 2003;200:4)
- Prognosis depends on patient age, international prognostic index score and genetic heterogeneity
- Recent studies indicate that DUSP22 rearrangements do not confer a better prognosis, in contrast to the initial study that showed a favorable prognosis (Haematologica 2023;108:1604, Br J Haematol 2019;186:e28)
- TP63 rearrangements poor survival rates (Blood 2014;124:1473)
- Loss of PRDM1 or TP53 poor outcome (Blood 2013;122:2683)
- Survival rates better than peripheral T cell lymphoma, not otherwise specified (Blood 2008;111:5496)
Case reports
- 13 year old girl with mediastinal ALK negative anaplastic large cell lymphoma (Oxf Med Case Reports 2019;2019:omz077)
- 21 year old man with a pulmonary abscess (Clin Nucl Med 2019;44:234)
- 53 year old man with AIDS with subcutaneous nodules on the scalp and axillae and diffuse lymphadenopathy (BMJ Case Rep 2019;12:e230641)
- 54 year old man misdiagnosed with Behçet disease (World J Clin Cases 2019;7:3377)
- 56 year old Asian man with right neck swelling for 3 months with fever and weight loss (Int J Surg Pathol 2017;25:502)
- 61 year old woman with endobronchial pseudocarcinomatous hyperplasia (Histopathology 2019 Nov 9 [Epub ahead of print])
- 69 year old woman with double hit of DUSP22 and TP63 rearrangements in anaplastic large cell lymphoma, ALK negative (Blood 2020;135:700)
- 69 year old woman presented with dyspnea and malaise (Case Rep Hematol 2018;2018:3465351)
- 73 year old man with recurrent thrombosis of his infrarenal aortic prosthesis (Virchows Arch 2019;474:763)
- 80 year old Japanese man with acute exacerbation of hypercalcemia (J Clin Exp Hematop 2019;59:22)
- 82 year old man with a history of cerebrovascular disease presented with weakness and iron deficiency anemia (In Vivo 2017;31:701)
- ALK negative anaplastic large cell lymphoma with Hodgkin-like cytomorphology and nuclear expression of PAX5 (Pathol Res Pract 2020;216:152724)
Treatment
- Chemotherapy with CHOP (cyclophosphamide, doxorubicin, vincristine and prednisone) or CHOP plus etoposide (CHOEP) (Curr Hematol Malig Rep 2018;13:135)
- Dose intensive regimens like hyper-CHOP and hyper-CVAD (hyperfractionated cyclophosphamide, vincristine, doxorubicin, dexamethasone, methotrexate and cytarabine) are also in use (Cancer 2005;103:2091)
- Upfront consolidative autologous stem cell transplantation at first complete remission (Blood Cancer J 2016;6:e452, J Clin Oncol 2012;30:3093)
- Brentuximab vedotin for relapsed / refractory disease (J Clin Oncol 2012;30:2190)
- Chimeric antigen receptor (CAR) T cell therapy and checkpoint inhibitors are now under evaluation (ClinicalTrials: NCT02581631 [Accessed 10 April 2020], ClinicalTrials: NCT02274584 [Accessed 10 April 2020])
Gross description
- Enlarged lymph nodes
- Firm fleshy mass
Microscopic (histologic) description
- Most of the time, morphologically indistinguishable from ALCL, ALK positive
- Effaced architecture with solid, cohesive sheets of neoplastic cells
- May show preserved lymph node architecture with neoplastic cells growing intrasinusoidally or only within the T cell areas
- Large cells with round to indented nuclei, deeply staining cytoplasm, with prominent Golgi zone
- Hallmark cells (cells with eccentric, horseshoe or kidney shaped nuclei)
- Small cells, as described in the small cell or lymphohistiocytic variant of ALCL, ALK positive, are uncommon
- Cases with DUSP22 rearrangements show smaller, monomorphic cells with prominent nucleoli and central nuclear pseudoinclusions (doughnut cells) (Haematologica 2019;104:e158)
- Cases positive for DUSP22 rearrangements lack a cytotoxic phenotype
- Cases with ERBB4 and COL29A1 expression show Hodgkin-like morphology (Blood 2016;127:221)
Microscopic (histologic) images
Contributed by Jayalakshmi Balakrishna, M.D. and Elaine S. Jaffe, M.D.
Contributed by Doan Minh Khuy, M.D.
Virtual slides
Cytology description
- Large atypical neoplastic cells, multinucleation / multilobated nuclei, prominent Golgi zone, basophilic cytoplasm
- Basophilic nucleoli, generally less prominent than seen in Hodgkin Reed-Sternberg cells
Positive stains
- Strong and diffuse uniform CD30 staining in all tumor cells (membrane and Golgi zone pattern, also cytoplasmic)
- Variable expression / loss of pan-T cell antigens: CD2+ and CD3+ more often than CD5+
- Almost always CD43+ and CD45+; can be used to distinguish from carcinoma
- Often CD4+, rarely CD8+
- TIA1, granzyme B, perforin, clusterin, fascin, EMA (variable)
- Cases with DUSP22 rearrangements tend to be less frequently positive for cytotoxic markers
Negative stains
Flow cytometry description
- Flow cytometry shows the anaplastic large cell lymphoma cells with high forward and side light scatter properties (consistent with large and complex cells) and high density CD45 expression simulating monocytes
- Tumor cells express CD30 and one or more of the T cell associated antigens (Arch Pathol Lab Med 2009;133:49)
Flow cytometry images
Molecular / cytogenetics description
- T cell receptor (TCR) clonal gene rearrangement in most cases, irrespective of T cell antigen expression
- DUSP22::IRF4 locus on 6p25.3 (referred to as DUSP22 rearrangements); t(6;7)(p25.3;q32.3) (Blood 2011;117:915)
- Recurrent rearrangement involving the TP63 gene in a minority of cases (Blood 2012;120:2280)
- Gains of the 1q41-qter and 6p21 are common cytogenetic aberrations (Br J Haematol 2008;140:516)
- ERBB4 and COL29A1 are expressed in 24% of ALK- ALCL, mutually exclusive with TP63 rearrangement (Blood 2016;127:221)
- STAT3 activating mutations in a subset of cases (Cancer Cell 2015;27:516)
Molecular / cytogenetics images
Sample pathology report
- Mass, left breast, excision:
- Anaplastic large cell lymphoma, ALK negative (see synoptic report)
Differential diagnosis
- ALCL, ALK positive:
- ALK+, younger age, less aggressive
- Classical Hodgkin lymphoma:
- Peripheral T cell lymphoma, NOS:
- Difficult differential, WHO recommends conservative approach (diagnose ALCL, ALK- only if very similar to ALCL, ALK+, except for ALK expression)
- Overall worse prognosis than ALCL, ALK-
- Primary cutaneous ALCL:
- Gene expression profiling shows that ALCL, ALK negative is closely related to primary cutaneous ALCL
- Much better prognosis, clinical correlation with staging necessary
- Breast implant associated ALCL:
- Breast implants, typically textured
- Triple negative genetic subtype
- Typically ALK- also
- Mycosis fungoides with CD30 expression:
- Presents as cutaneous patches and can progress to plaques, tumors and erythroderma
- Band-like papillary dermal lymphoid infiltrate
- Intraepidermal lymphocytes out of proportion with spongiosis (epidermotropism) with or without Pautrier microabscesses
Additional references
Practice question #1
What is the morphologic characteristic of anaplastic large cell lymphoma, ALK negative with DUSP22-IRF4 rearrangement?
- Eosinophilia
- Hodgkin-like cells
- Prominent nucleoli and intranuclear inclusions (doughnut cells)
- Small cell morphology
Practice answer #1
C. Prominent nucleoli and intranuclear inclusions (doughnut cells)
Comment Here
Reference: Anaplastic large cell lymphoma, ALK negative
Comment Here
Reference: Anaplastic large cell lymphoma, ALK negative
Practice question #2
What is a prognostic factor in anaplastic large cell lymphoma, ALK negative?
- Age of the patient
- Gender of the patient
- Mitotic count
- Tumor necrosis
Practice answer #2